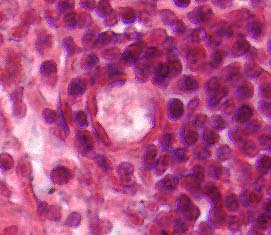

When a person is sick, a piece of the affected tissue (a biopsy) may be surgically removed to be examined by a pathologist. The pathologist is trained to process the biopsy to best visualize the sample to help diagnose the cause of the illness. Histology is the study of healthy tissue and pathology includes the study of unhealthy tissue. A pathologist can use a variety of dyes to stain the tissue contrasting colors to help visualize the cells. Alternatively, the pathologist may want to use antibodies to detect particular ptoeins. The use of antibody labeling has several names (immunohistochemistry, immunoflourescence and immunocytochemistry) but the procedures are very similar and there is a methods page devoted to antibody labeling of biopsies.
For example, a patient suffering from muscle atrophy or cancer might have a biopsy removed and the affected tissues can be visualized histologically. If the pathologist wants to visualize the cells and tissue, the biopsy will be stained to help visualize the nuclei and proteins. For this staining, most biopsies are labeled with hematoxylin (stains proteins red) and eosin (stains nuclei dark blue/purple) which makes the tissue easier to see. Below is an example of a region of a lymphnode where B cells can be found (see Chapter 5). Below the image is a link to the interactive histology site called Hyperlinked Human Histology where you can choose a tissue and zoom in to see histology slides at different magnifications.

Figure 1. Histological images of blood vessels in a lymph node. Capillary in first panel and arteriole in second panel. B cells can enter the lymph node through these blood vessels.





Figure 2. Five histological images of a germinal center where B cells congregate during an infection.
Hyperlinked Human Histology web site
© Copyright 2002 Department of Biology, Davidson College, Davidson, NC 28036
Send comments, questions, and suggestions to: macampbell@davidson.edu